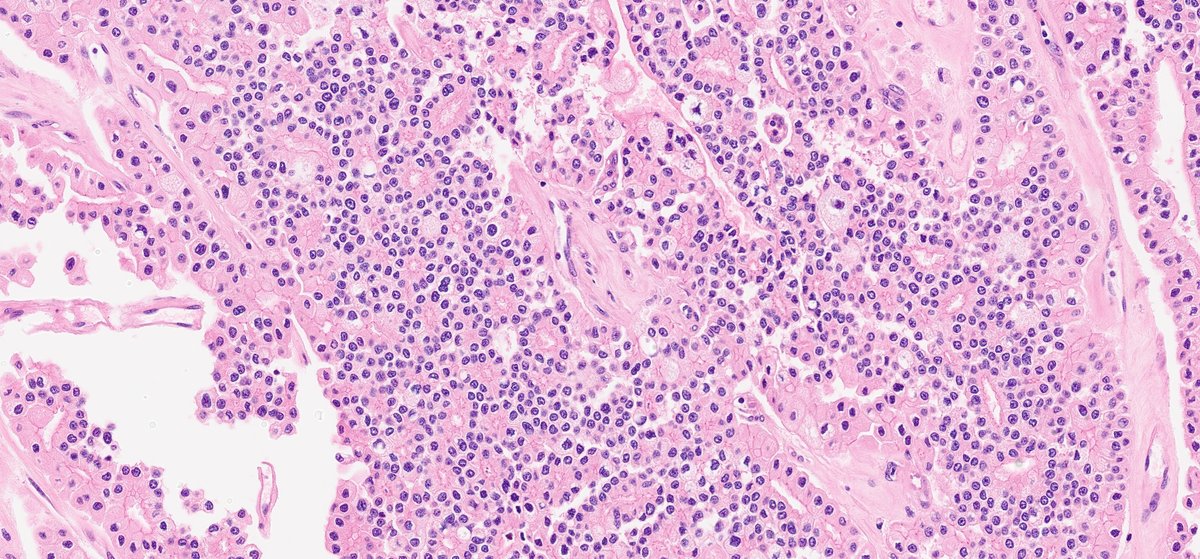
#GUpath nephrectomy:
uncommon adenomatous pattern chromophobe RCC

usually👀background more typical chromoRCC elements &amp; stains as chromoRCC

😲when not recognized or on core bx🚨, DDx widens significantly (other pink renal tumors, urothelial ca w/glandular diff, mets)

⏬ref's
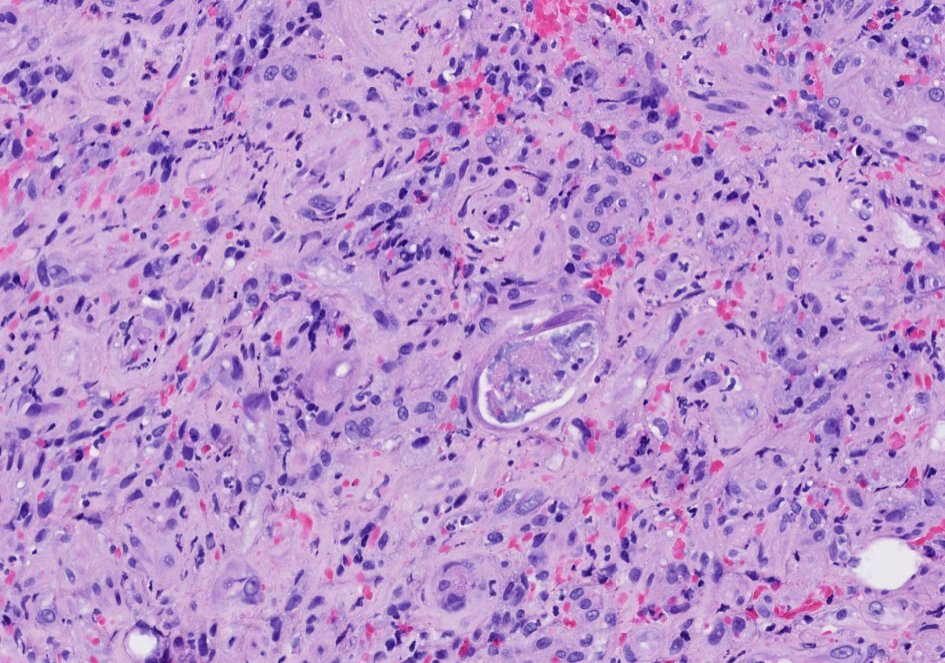
Non-neoplastic gastric pathology problems
57 yo M with a gastric ulcer and history of liver transplant
Malignant...or maybe not?

Final diagnosis: 90Y-TheraSpheres associated gastric ulcer

Clues for diagnosis
-Therasphere beads (mimic air-bubble artifact) against a background of

Muhammad Azam
@majju33
ID: 235698976
08-01-2011 21:47:25
245 Tweet
128 Takipçi
519 Takip Edilen












Muhammad Azam Etan Marks, DO David Terrano Tim McCalmont Allison Osmond MD MSc FRCPC 🕊 🌎 🕊 Van-Hung Nguyen MD 🇺🇦🌻 Olaleke Folaranmi Jonathan He Lorand Kis Mariantonieta Tirado Marcelasaeblima. Med Amine Gonzalo De Toro Pepe Jiménez Heffernan Joseph Susa, DO Clay Cockerell Jason L. Hornick, M.D., Ph.D. @Hemepathguy HemepathUPMC Fantastic case Etan. This is beautiful! The lymphoblasts are the killer ( pitfalls to be mistaken as low grade B cell cutaneous lymphoma). So T cell Acute lymphoblastic leukemia involving skin!!!